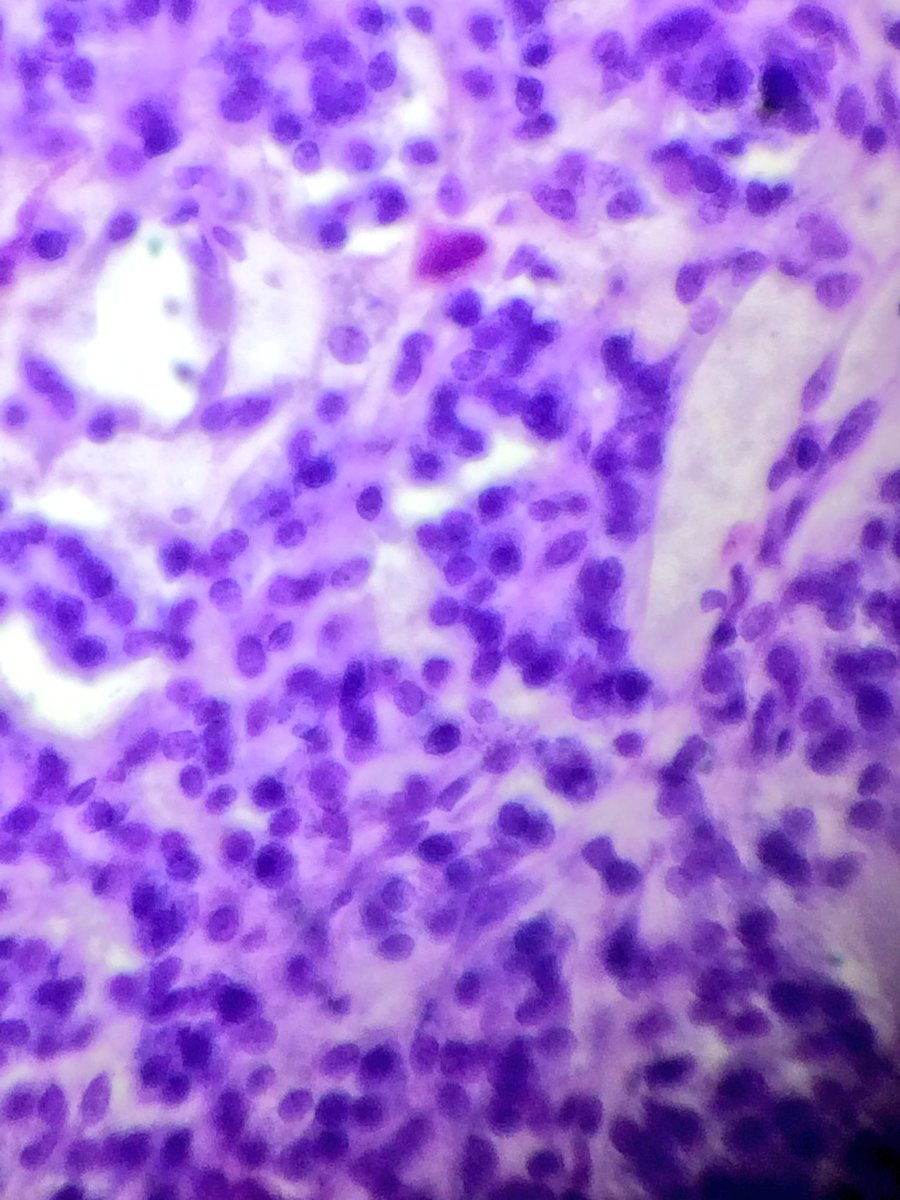
sam_albadri's tweet image. Carotid body paraganglioma #Tolblue @PathologyIsCool @raghupillappa @TheUSCAP @UABPathology @edusqo @DraEosina #patholo

#patholo search results
Speech Language Patholo Job (Atlanta, GA) zillionjobs.com/Job-2163346.ht… #Language #Patholo #job #jobs #Atlanta
Acaaabei de chegar do @ragazzoonline com o #Patholo, #Modesto, #Henrique, #MarcelinhoDoPalio e o irmão do henrique!
Get Online Test Booking Website with Pathology Software #Shorts #Patholo... youtu.be/BK5vyEfGYF0 via @YouTube
cow : bapak qm jualan softex ya,, cew : kok tau?? Cow: soal.a qm udah membalut luka di hati ini,, #patholo
Lepromatous leprosy. Mycobacterium Leprae infection in immune compromised. Granulatomous inflammation packed with organisms; +/-perineural inv. Nerve dmg --> can't feel that I just stepped on a nail -> infection -->deformity. Armadillo carrier. #dermatology #dermpath #patholo



RT Value Of Healthcare = Connections In Your Network | by CancerGeek bit.ly/1Sjc76D #radiology #patholo…
Value Of Healthcare = Connections In Your Network | by @CancerGeek bit.ly/1Sjc76D #radiology #pathology #plasticsurgery
Small break rock painting with Shay Warriors @ShayAfter for cancer survivors. @TheUSCAP #USCAP25 #patholo

Sigmoid polyp. Dysplasias vs. Fibrosis 2nd to ruptured crypt . How reproducible is desmoplastic reaction? #gipathology #patholo

Tomei logo um enquadro com o #Patholo e o maldito ta logo foragido! Meteu o loko q tava sem RG! #DeuNadaGraçasADeus
Familiarity breeds contempt RT @usmlemexico MEN IIa(2pm) Pheochromocytoma, hyperParathyroidism, Medullary carcinoma of the thyroid #patholo
#SubmitAbstract - Digital Pathology UCGConferences , Now the Registration is open for the CME/CPD accredited 10th World Digital Pathology & AI UCGCongres on April 04-06, 2023 in Berlin, Germany. We are left with a few slots, join ASAP digitalpathology.ucgconferences.com/submit-abstrac… #Pathology #Patholo

... - #Naples , FL (getpathologistjobs.com/speech-languag…) Get Pathologist Jobs #Patholo
Speech Language Pathologist Patholo Job (Saint Helens, OR) zillionjobs.com/Job-6546397.ht… #Pathologist #Patholo #job #jobs #Saint Helens
👉𝐒𝐡𝐨𝐩 𝐧𝐨𝐰 & 𝐠𝐞𝐭 𝟏𝟎% 𝐃𝐢𝐬𝐜𝐨𝐮𝐧𝐭 bit.ly/3FI2JpG 𝗨𝗹𝘁𝗿𝗮𝘀𝗼𝘂𝗻𝗱 𝗶𝗻 𝗙𝗶𝗿𝘀𝘁 𝗧𝗿𝗶𝗺𝗲𝘀𝘁𝗲𝗿 by Dr. Tanveer Khalid Zubairi. ✅Sample chapter & table of content can be viewed here: bit.ly/3fKDnwS #Ultrasound #anatomy #patholo

Did you know about Hallux Valgus? It's a common foot condition where the big toe deviates towards the other toes. This can cause discomfort and affect your mobility. #patholo #FootHealth #Podiatry #Orthopedics #HealthAwareness"

Speech Language Pathologist Patholo Job (South Milwaukee, WI) zillionjobs.com/Job-6848230.ht… #Pathologist #Patholo #job #jobs #South Milwaukee
Small break rock painting with Shay Warriors @ShayAfter for cancer survivors. @TheUSCAP #USCAP25 #patholo

𝗨𝗹𝘁𝗿𝗮𝘀𝗼𝘂𝗻𝗱 𝗶𝗻 𝗙𝗶𝗿𝘀𝘁 𝗧𝗿𝗶𝗺𝗲𝘀𝘁𝗲𝗿 ✅Sample chapter & table of content can be viewed here: bit.ly/3fKDnwS 👉𝐒𝐡𝐨𝐩 𝐧𝐨𝐰 & 𝐠𝐞𝐭 𝟏𝟎% 𝐃𝐢𝐬𝐜𝐨𝐮𝐧𝐭 bit.ly/3FI2JpG #Ultrasound #anatomy #patholo


Sigmoid polyp. Dysplasias vs. Fibrosis 2nd to ruptured crypt . How reproducible is desmoplastic reaction? #gipathology #patholo

Did you know about Hallux Valgus? It's a common foot condition where the big toe deviates towards the other toes. This can cause discomfort and affect your mobility. #patholo #FootHealth #Podiatry #Orthopedics #HealthAwareness"

Digital Pathology has been discussed for years and yet we can count on our fingers the number of institutions that are actually completely digital. Join me in the discussion on what are the real hurdles on the ground level and possible solutions! #patholo…lnkd.in/eqDEsfBs
#SubmitAbstract - Digital Pathology UCGConferences , Now the Registration is open for the CME/CPD accredited 10th World Digital Pathology & AI UCGCongres on April 04-06, 2023 in Berlin, Germany. We are left with a few slots, join ASAP digitalpathology.ucgconferences.com/submit-abstrac… #Pathology #Patholo

Dermatofibroma (DF). A 20-year-old female with well-defined red-brown firm papule on dorsal surface of the foot. Case by @MalekAsfarMD Click ALT for more details. #pathology #pathologists #patholo #dermpath #dermtwitter #dermatology #dermatologia @ASDPTweets @IntSocDermpath



#SubmitAbstract - Digital Pathology UCGConferences , Now the Registration is open for the CME/CPD accredited 10th World Digital Pathology & AI UCGCongres on April 04-06, 2023 in Berlin, Germany. We are left with a few slots, join ASAP digitalpathology.ucgconferences.com/submit-abstrac… #Pathology #Patholo

Membership in @PapSociety can provide you #pathologists and #Trainee in #patholo with fulfilling relationships, professional networking and much more. Check it out by scanning the code #cytopath #PathTwitter
Are you a Pathology trainee? Are you a Pathologist? UCGConferences is organizing the 10th World Digital Pathology & AI UCGCongress on April 04-06, 2023 in Berlin, Germany We would like to invite you to attend our Conference. By registering here: digitalpathology.ucgconferences.com/registration #Patholo

Pathology Software and Patient Entry #shorts #pathologysoftware #patholo... youtu.be/vwL_RUOmM8w via @YouTube
👉𝐒𝐡𝐨𝐩 𝐧𝐨𝐰 & 𝐠𝐞𝐭 𝟏𝟎% 𝐃𝐢𝐬𝐜𝐨𝐮𝐧𝐭 bit.ly/3FI2JpG 𝗨𝗹𝘁𝗿𝗮𝘀𝗼𝘂𝗻𝗱 𝗶𝗻 𝗙𝗶𝗿𝘀𝘁 𝗧𝗿𝗶𝗺𝗲𝘀𝘁𝗲𝗿 by Dr. Tanveer Khalid Zubairi. ✅Sample chapter & table of content can be viewed here: bit.ly/3fKDnwS #Ultrasound #anatomy #patholo

Speech by Dr. Reena Nakra on "Digital Pathology Implementation in a High Volume Reference Laboratory " at the CME/CPD accredited 11EPUCG2022 on May 09-10, 2022, Online You can access the live presentation by registering here pathology.universeconferences.com/registration/ #digitalpathology #patholo

Don’t miss the opportunity to share your scientific excellence and be a part of the expert gathering CME/CPD accredited 11th Emirates Pathology & Digital Pathology Utilitarian Conference, pathology.universeconferences.com/submit-abstrac… Hurry Up Register now: pathology.universeconferences.com/registration/ #Pathology #Patholo

Sigmoid polyp. Dysplasias vs. Fibrosis 2nd to ruptured crypt . How reproducible is desmoplastic reaction? #gipathology #patholo

Did you know about Hallux Valgus? It's a common foot condition where the big toe deviates towards the other toes. This can cause discomfort and affect your mobility. #patholo #FootHealth #Podiatry #Orthopedics #HealthAwareness"

Lepromatous leprosy. Mycobacterium Leprae infection in immune compromised. Granulatomous inflammation packed with organisms; +/-perineural inv. Nerve dmg --> can't feel that I just stepped on a nail -> infection -->deformity. Armadillo carrier. #dermatology #dermpath #patholo



Don’t miss the opportunity to share your scientific excellence and be a part of the expert gathering CME/CPD accredited 11th Emirates Pathology & Digital Pathology Utilitarian Conference, pathology.universeconferences.com/submit-abstrac… Hurry Up Register now: pathology.universeconferences.com/registration/ #Pathology #Patholo

Small break rock painting with Shay Warriors @ShayAfter for cancer survivors. @TheUSCAP #USCAP25 #patholo

RT @jainprantesh: RT @CCIPD_Case: From @cwru The Daily: @CWRUBME Anant Madabhushi (@anantm) co-authors paper "Applications of machine learning in drug discovery and development." bit.ly/cwrudaily072619 nature.com/articles/s4157… #MachineLearning #patholo…

#SubmitAbstract - Digital Pathology UCGConferences , Now the Registration is open for the CME/CPD accredited 10th World Digital Pathology & AI UCGCongres on April 04-06, 2023 in Berlin, Germany. We are left with a few slots, join ASAP digitalpathology.ucgconferences.com/submit-abstrac… #Pathology #Patholo

#CFA Track 14 Cardiovascular Pathology The deadline abstract call is February 15, 2022 for the CME/CPD accredited 11th Emirates Pathology & Digital Pathology Utilitarian Conference on MAY 9-10, 2022, Online Submit your abstract here : pathology.universeconferences.com/submit-abstrac… #Pathology #Patholo

Carotid body paraganglioma #Tolblue @PathologyIsCool @raghupillappa @TheUSCAP @UABPathology @edusqo @DraEosina #patholo

Tumor Chip Incorporates Vascular System for More Realistic Drug Testing #Medicine #Oncology #Patholo #fitness #health #training #healthy #healthylifestyle #cardio #healthyliving #healthylife #medicine #healthcare #AI #cardioworkout #cardiologia #card medgadget.com/2020/01/tumor-…

𝗨𝗹𝘁𝗿𝗮𝘀𝗼𝘂𝗻𝗱 𝗶𝗻 𝗙𝗶𝗿𝘀𝘁 𝗧𝗿𝗶𝗺𝗲𝘀𝘁𝗲𝗿 ✅Sample chapter & table of content can be viewed here: bit.ly/3fKDnwS 👉𝐒𝐡𝐨𝐩 𝐧𝐨𝐰 & 𝐠𝐞𝐭 𝟏𝟎% 𝐃𝐢𝐬𝐜𝐨𝐮𝐧𝐭 bit.ly/3FI2JpG #Ultrasound #anatomy #patholo


👉𝐒𝐡𝐨𝐩 𝐧𝐨𝐰 & 𝐠𝐞𝐭 𝟏𝟎% 𝐃𝐢𝐬𝐜𝐨𝐮𝐧𝐭 bit.ly/3FI2JpG 𝗨𝗹𝘁𝗿𝗮𝘀𝗼𝘂𝗻𝗱 𝗶𝗻 𝗙𝗶𝗿𝘀𝘁 𝗧𝗿𝗶𝗺𝗲𝘀𝘁𝗲𝗿 by Dr. Tanveer Khalid Zubairi. ✅Sample chapter & table of content can be viewed here: bit.ly/3fKDnwS #Ultrasound #anatomy #patholo

Speech by Dr. Reena Nakra on "Digital Pathology Implementation in a High Volume Reference Laboratory " at the CME/CPD accredited 11EPUCG2022 on May 09-10, 2022, Online You can access the live presentation by registering here pathology.universeconferences.com/registration/ #digitalpathology #patholo

Are you a Pathology trainee? Are you a Pathologist? UCGConferences is organizing the 10th World Digital Pathology & AI UCGCongress on April 04-06, 2023 in Berlin, Germany We would like to invite you to attend our Conference. By registering here: digitalpathology.ucgconferences.com/registration #Patholo

Dermatofibroma (DF). A 20-year-old female with well-defined red-brown firm papule on dorsal surface of the foot. Case by @MalekAsfarMD Click ALT for more details. #pathology #pathologists #patholo #dermpath #dermtwitter #dermatology #dermatologia @ASDPTweets @IntSocDermpath



Something went wrong.
Something went wrong.
United States Trends
- 1. #LoveYouTeacherSeriesEP3 N/A
- 2. Good Saturday N/A
- 3. #UberEats N/A
- 4. Jupiter's Best N/A
- 5. Hoodies N/A
- 6. #Caturday N/A
- 7. No Kings N/A
- 8. #TakoTori1stConcert N/A
- 9. #ALWAYS_WITH_7 N/A
- 10. Iowa State N/A
- 11. Sami N/A
- 12. Melo N/A
- 13. Kiara N/A
- 14. Yemen N/A
- 15. Rick Barnes N/A
- 16. Jane N/A
- 17. Houthis N/A
- 18. Michigan State N/A
- 19. Izzo N/A
- 20. Bob Hope N/A





































































